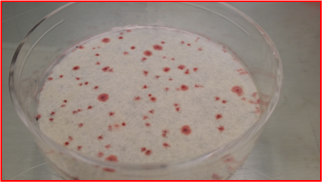
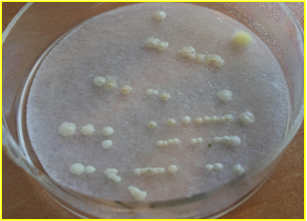

DryPlates TSA-Crom y DryPlates SDA-Caf son placas preparadas de medio deshidratado estéril para recuento en 1 ml sin tener que fundir medios
¡Placas preparadas de medio deshidratado estéril!
Absorben en frío 1 ml de muestra en masa.
Las DryPlates® son placas preparadas, estériles y listas para su uso inmediato, con 2 años de caducidad desde fabricación,
al estar elaboradas con medio deshidratado, que se hidrata precisamente mediante la muestra en el momento de inocularla.
La gelificación en frío (a diferencia del clásico medio con Agar-agar, que precisa hervir para gelificar) se consigue con un desarrollo de MICROKIT denominado “Hidragar”,
que ahorra el hervido-fusión-enfriado-a-45ºC y las 2 horas de todo este trabajo propio del medio clásico.
El reparto inmediato de la muestra y la distribución homogénea del medio se consiguen gracias al Disco Nutriente,
un disco fibroso de malla muy fina que retiene juntos el medio de cultivo en polvo y la muestra.
Enhorabuena por haber adquirido el sustituto del Siglo XXI de los medios deshidratados y de los medios preparados hidratados!
MODO DE EMPLEO
- Con unas pinzas, sacar un disco nutriente de su bolsa y colocar en la tapa de una placa DryPlates® recién abierta.
- Añadir a la base de placa 1 ml de muestra líquida (o su dilución) bien centrada (mejor que la muestra no toque las paredes internas de la placa, para que la autodifusión sea mucho más rápida y homogénea y no se formes islas secas marginales).
- Voltear la tapa con disco nutriente para volver a cerrar la placa, con cuidado para que el disco nutriente caiga centrado sobre la muestra; de este modo se repartirá homogéneamente en un instante:
Si se prefiere, puede tomar el disco nutriente con unas pinzas y colocarlo directamente sobre el ml de muestra, previamente dispensado en el centro de la placa):
No añada la muestra sobre el disco nutriente, ya que no difundirá homogéneamente. La formación de “islas secas” sin muestra sólo debe preocupar si éstas son muy grandes, ya que al incubar las pequeñas desaparecerán y además el número de colonias por placa en 1 ml de muestra será el mismo con o sin ellas.
INCUBACIÓN
- Incubar en estufa, IMPORTANTE: en atmósfera húmeda (dejar 4 vasos llenos de agua en la estufa, uno en cada esquina), sin voltear las placas (el disco abajo) para que no se fugue parte de muestra durante la incubación.
- Nunca incube las DryPlates® directamente sobre la bandeja de la estufa, intercale dos placas vacías (como “podio base porta-placas” para poner entre la torre de placas y la base metálica de la estufa) para que la DryPlate® no se seque durante la incubación por el exceso de calor del metal;
- igualmente no deje que la torre de placas toque la paredes de la estufa. Las condiciones de incubación (tiempo y temperatura) son las estándar de cada medio: bacterias 22-37ºC, 1-3 días, hongos 21-25ºC, 3-5 días.
- Antes de leer, es muy importante verificar que la superficie de la placa sigue húmeda.
- Leer los resultados (recuentos o aislamientos) buscando sólo las colonias diana, que crecen del color indicado para cada medio en la etiqueta de su caja:
- bacterias rojas en DryPlates®-TSA cromogénico, mohos filamentosos-algodonosos en DryPlates®-SDA Caf y levaduras no filamentosas ni algodonosas en DryPlates®-SDA Caf.
- Para uso en 1 mL de agua, añadir 1 ml de la muestra de agua centrada en la DryPlates®-TSA (o mejor en DryPlates®-R2A). En los demás parámetros del agua, y/o para mayores volúmenes, prehidratarlas poniendo 1 ml de agua estéril en la placa, añadir el disco nutriente y, una vez empapado, poner encima de éste la membrana filtrada por los 100-250 ml de muestra.
- Para superficies, estriar un hisopo con el que haya barrido una muestra de superficies, sobre la DryPlates®, previamente hidratada con 1 ml de agua estéril.
- Para aires dejar la DryPlates® de cualquier medio, previamente hidratada con 1 ml de agua estéril, abierta durante 10-15 minutos en los puntos críticos de la sala, para realizar una estimación “de campo” de la flora ambiental
- (aunque es mejor usar un muestreador tipo Microflow o MBS para obtener recuentos por m3 de aire)
CONSERVACIÓN Y PRECAUCIONES DE USO
Almacenar a temperatura ambiente (ideal 15-25ºC) ¡no en nevera!, ya que en ésta la humedad es más fácil que prehidrate y estropee los discos nutrientes.
Eso sí, es imprescindible almacenar en lugar muy seco y oscuro, ya que la humedad y la luz dañan irreversiblemente los medios de cultivo deshidratados.
Si trabaja en zonas de alta humedad atmosférica, almacene las DryPlates®, bien cerradas en su bolsa, dentro de una caja hermética “tupper” con silicagel o sacos antihumedad (ej: MICROKIT VRB747).
NUEVA GAMA
-DryPlates®-TSA cromogénico: DPP020- (caja 60 u) y DPP020+ (caja 1200 u): Recuento total en cosméticos, TSA (ISO 21149) cromogénico, colonias rojas que para mejor visión, contrastan con el medio color crema y con las partículas de la muestra. Dcha: Mix de aerobios totales.
-DryPlates®-SDA Caf: DPP021- (caja 60 u) y DPP021+ (caja 1200 u): Recuento de hongos (levaduras y mohos) en cosméticos, medio color crema Sabouraud Dextrosa Cloranfenicol Agar (ISO 16212), colonias de sus colores naturales (Izda: Levadura Candida albicans; Dcha: Moho Aspergillus niger).
NOTAS
Otros muchos medios en DryPlates®: Aerobios totales (medios diferentes en alimentos, en cosméticos, en aguas, en aguas oligotróficas, en medicamentos, en bebidas alcohólicas),
Levaduras y Mohos (en alimentos, en cosméticos, en aguas, en medicamentos),
Enterobacterias (VRBG o cromogénico),
Coliformes, Coliformes y E.coli, E.coli,
Staphylococcus aureus,
Bacillus cereus,
Pseudomonas aeruginosa,
Burkholderia cepacia,
Candida albicans,
Enterococos fecales (SB ó KAA a elegir),
Salmonella spp. (Cromosalm y XLD),
Vibrio parahaemolyticus-Vibrio cholerae,
Antiobiograma cromogénico,
UTIs…
Si necesita otros medios en formato DryPlates® podemos diseñarlos especialmente para Ud.
El usuario final es el único responsable de la eliminación de los microorganismos según la legislación medioambiental vigente. Autoclavar antes de desechar a la basura.
Diseño y fabricación 100% españoles. Derechos de explotación de la PATENTE concedidos en exclusiva a Laboratorios MICROKIT, S.L. tras más de 23 años de ensayos y mejoras para poder ofrecerle el mejor y más versátil producto de estas características. Validado en base a la Norma UNE-EN-ISO 16140, con recuperaciones equivalentes (>90%) a los mismos medios clásicos agarizados.
https://www.microkit.es/fichas/Dry-Plates-TSA-crom-y-SDA-Caf-Prospecto.pdf
Si desea más información sobre nuestros DryPlates®-TSA-Crom y SDA-Caf rellene nuestro formulario de contacto http://www.medioscultivo.com/contacto . O si lo prefiere póngase en contacto con nosotros a través de nuestro correo electrónico microkit@microkit.es o por teléfono en el nº 91-897 46 16
Haga sus consultas de este medio en: microkit@microkit.es
Haga sus pedidos de este medio en: pedidos@microkit.es
En este vídeo puedes entender mejor la hazaña de las DryPlates® y cómo usarlas: